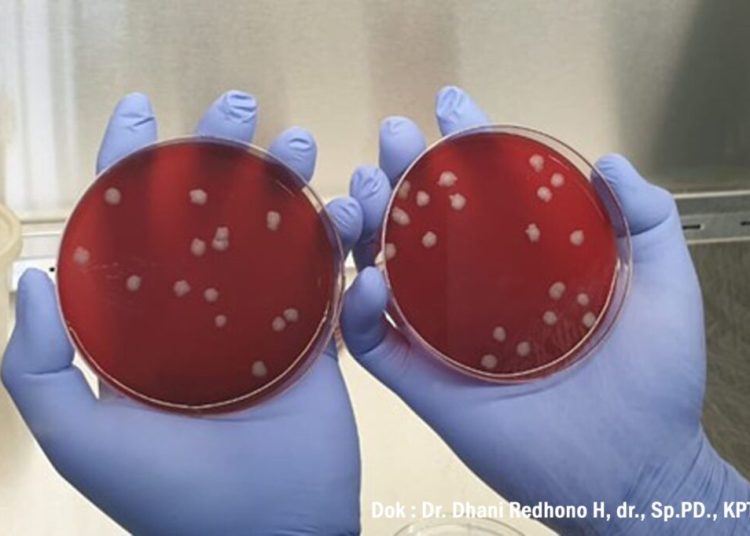
Pakar Kesehatan FK UNS Himbau Masyarakat untuk Mewaspadai Penyakit Antraks – Universitas Sebelas Maret

UNS— Antraks adalah salah satu penyakit yang bersumber dari binatang (Zoonosis) yang disebabkan oleh bakteri Bacillus Anthracis dan membutuhkan perhatian serius dalam penanganannya. Di Indonesia sendiri telah terjadi beberapa kasus antraks yang disebabkan oleh kurangnya pengetahuan masyarakat tentang penyakit ini. Masyarakat yang sering berinteraksi dengan hewan ternak seperti sapi atau kerbau dan produk turunannya, mempunyai risiko yang besar tertular bakteri antraks ini. Meski demikian, tidak menutup kemungkinan hewan liar juga dapat membawa bakteri ini dan menularkannya ke manusia.
Meskipun kasus antraks jarang terjadi namun penyakit ini adalah penyakit serius yang dapat mengakibatkan kematian. Oleh karenanya, cukup penting untuk meningkatkan pengetahuan masyarakat tentang bahaya penyakit antraks agar bisa menjadi deteksi dini terhadap penyebaran penyakit ini.
Pakar Kesehatan yang juga Dosen Fakultas Kedokteran (FK) Universitas Sebelas Maret (UNS) Surakarta, Dr. Dhani Redhono Harioputro, dr., Sp.PD., KPTI, mengatakan, bakteri antraks ini hanya bisa ditularkan dari hewan ke manusia dan sampai sekarang belum ada kasus untuk penularan antar manusia.
“Khusus untuk antraks ini adalah dia hanya satu arah jadi dari hewan ke manusia tidak bisa dibalik dan kejadiannya di Indonesia itu paling sering adalah karena orang memakan daging hewan yang terinfeksi antraks,” terang Dr. Dhani, Kamis (13/6/2024).
Lebih lanjut dijelaskan oleh Dr. Dhani, jika bakteri antraks ini sangatlah unik karena setelah masuk ke dalam tubuh bisa berubah dari bakteri menjadi bentuk spora dan proses masuknya spora antraks ini bisa melalui beberapa cara.
“Infeksi ini bisa melalui kulit atau cutaneous anthrax, melalui saluran pernafasan atau inhaled anthrax dan melalui saluran pencernaan atau gastrointestinal anthrax. Oleh karenanya penting untuk memasak daging sampai benar-benar matang karena antraks ini akan mati pada suhu 100 derajat celcius selama lebih 15 menit,” imbuhnya.


Proses infeksi antraks yang paling besar adalah melalui kulit atau cutaneous anthrax yang mencakup hampir 95% kasus yang terjadi. “Ada beberapa gejala yang dialami oleh penderita antraks yang terinfeksi melalui kulit, diawali dengan merasa gatal dan nyeri pada kulit kemudian muncul warna kemerahan berbintik pada kulit lalu kulit akan terbuka dan berubah menjadi eschar kehitaman disertai dengan edema atau bengkak. Harus ada dua ini, eschar dan edema untuk kita bisa mencurigai bahwa itu antraks kulit,” jelas Dr. Dhani.
Lalu untuk infeksi inhaled anthrax itu gejalanya sama dengan kasus orang pneumonia, bedanya adalah kalau pada inhaled anthrax mempunyai progresivitasnya yang sangat cepat. “Bisa dalam waktu kurang dari 4 hari setelah terinfeksi, pasien itu meninggal dunia,” lanjutnya.
Sedangkan infeksi gastrointestinal anthrax biasanya dikarenakan mengkonsumsi daging yang terinfeksi antraks. Gejalanya hampir sama dengan kasus keracunan makanan namun yang membedakan adalah progresivitasnya lebih cepat. Diawali dengan rasa mual-mual, muntah darah hingga meninggal dunia hanya membutuhkan waktu 4-5 hari. Tingkat mortalitas pada kasus ini bisa mencapai 95-99% pasien yang terinfeksi akan meninggal dunia.
Spora antraks dapat bertahan didalam tanah hingga belasan tahun sehingga perlu ada perlakuan khusus pada hewan yang mati karena antraks. “Jadi prosedurnya, bangkai hewan dikubur pada kedalaman minimal 1,5 meter hingga 2 meter lalu diatasnya diplester (cor) dan diberi tanda jika dibawahnya dikuburkan hewan yang terinfeksi antraks. Ini penting karena spora antraks dapat muncul dipermukaan tanah dalam waktu 10 hingga 12 tahun sehingga mencegah tanah tempat dikuburkan hewan itu dibongkar oleh orang,” terang Dr. Dhani.
Pencegahan penyebaran penyakit ini telah dan terus dilakukan oleh lintas sektor baik sektor kesehatan hewan, sektor kesehatan manusia dan sektor pertanian dan peternakan. Penguatan koordinasi, kolaborasi dan komunikasi Warga Berita 3 sektor tadi diharapkan bisa mengendalikan penyebaran penyakit antraks ini. Humas UNS
Redaktur: Dwi Hastuti
UNS— Antraks adalah salah satu penyakit yang bersumber dari binatang (Zoonosis) yang disebabkan oleh bakteri Bacillus Anthracis dan membutuhkan perhatian serius dalam penanganannya. Di Indonesia sendiri telah terjadi beberapa kasus antraks yang disebabkan oleh kurangnya pengetahuan masyarakat tentang penyakit ini. Masyarakat yang sering berinteraksi dengan hewan ternak seperti sapi atau kerbau dan produk turunannya, mempunyai risiko yang besar tertular bakteri antraks ini. Meski demikian, tidak menutup kemungkinan hewan liar juga dapat membawa bakteri ini dan menularkannya ke manusia.
Meskipun kasus antraks jarang terjadi namun penyakit ini adalah penyakit serius yang dapat mengakibatkan kematian. Oleh karenanya, cukup penting untuk meningkatkan pengetahuan masyarakat tentang bahaya penyakit antraks agar bisa menjadi deteksi dini terhadap penyebaran penyakit ini.
Pakar Kesehatan yang juga Dosen Fakultas Kedokteran (FK) Universitas Sebelas Maret (UNS) Surakarta, Dr. Dhani Redhono Harioputro, dr., Sp.PD., KPTI, mengatakan, bakteri antraks ini hanya bisa ditularkan dari hewan ke manusia dan sampai sekarang belum ada kasus untuk penularan antar manusia.
“Khusus untuk antraks ini adalah dia hanya satu arah jadi dari hewan ke manusia tidak bisa dibalik dan kejadiannya di Indonesia itu paling sering adalah karena orang memakan daging hewan yang terinfeksi antraks,” terang Dr. Dhani, Kamis (13/6/2024).
Lebih lanjut dijelaskan oleh Dr. Dhani, jika bakteri antraks ini sangatlah unik karena setelah masuk ke dalam tubuh bisa berubah dari bakteri menjadi bentuk spora dan proses masuknya spora antraks ini bisa melalui beberapa cara.
“Infeksi ini bisa melalui kulit atau cutaneous anthrax, melalui saluran pernafasan atau inhaled anthrax dan melalui saluran pencernaan atau gastrointestinal anthrax. Oleh karenanya penting untuk memasak daging sampai benar-benar matang karena antraks ini akan mati pada suhu 100 derajat celcius selama lebih 15 menit,” imbuhnya.


Proses infeksi antraks yang paling besar adalah melalui kulit atau cutaneous anthrax yang mencakup hampir 95% kasus yang terjadi. “Ada beberapa gejala yang dialami oleh penderita antraks yang terinfeksi melalui kulit, diawali dengan merasa gatal dan nyeri pada kulit kemudian muncul warna kemerahan berbintik pada kulit lalu kulit akan terbuka dan berubah menjadi eschar kehitaman disertai dengan edema atau bengkak. Harus ada dua ini, eschar dan edema untuk kita bisa mencurigai bahwa itu antraks kulit,” jelas Dr. Dhani.
Lalu untuk infeksi inhaled anthrax itu gejalanya sama dengan kasus orang pneumonia, bedanya adalah kalau pada inhaled anthrax mempunyai progresivitasnya yang sangat cepat. “Bisa dalam waktu kurang dari 4 hari setelah terinfeksi, pasien itu meninggal dunia,” lanjutnya.
Sedangkan infeksi gastrointestinal anthrax biasanya dikarenakan mengkonsumsi daging yang terinfeksi antraks. Gejalanya hampir sama dengan kasus keracunan makanan namun yang membedakan adalah progresivitasnya lebih cepat. Diawali dengan rasa mual-mual, muntah darah hingga meninggal dunia hanya membutuhkan waktu 4-5 hari. Tingkat mortalitas pada kasus ini bisa mencapai 95-99% pasien yang terinfeksi akan meninggal dunia.
Spora antraks dapat bertahan didalam tanah hingga belasan tahun sehingga perlu ada perlakuan khusus pada hewan yang mati karena antraks. “Jadi prosedurnya, bangkai hewan dikubur pada kedalaman minimal 1,5 meter hingga 2 meter lalu diatasnya diplester (cor) dan diberi tanda jika dibawahnya dikuburkan hewan yang terinfeksi antraks. Ini penting karena spora antraks dapat muncul dipermukaan tanah dalam waktu 10 hingga 12 tahun sehingga mencegah tanah tempat dikuburkan hewan itu dibongkar oleh orang,” terang Dr. Dhani.
Pencegahan penyebaran penyakit ini telah dan terus dilakukan oleh lintas sektor baik sektor kesehatan hewan, sektor kesehatan manusia dan sektor pertanian dan peternakan. Penguatan koordinasi, kolaborasi dan komunikasi Warga Berita 3 sektor tadi diharapkan bisa mengendalikan penyebaran penyakit antraks ini. Humas UNS
Redaktur: Dwi Hastuti